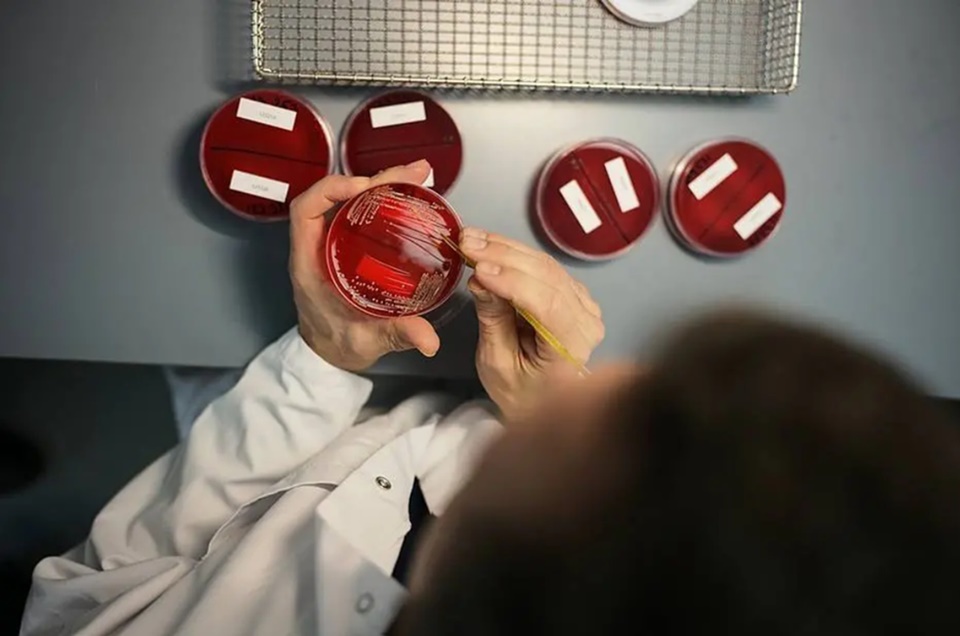

A Food and Drug Administration (FDA), agência federal do Departamento de Saúde e Serviços Humanos dos Estados Unidos, responsável pela liberação de alimentos e medicamentos no país, aprovou uma nova droga para combater o câncer de pâncreas em estágio avançado, a Lynparza.
Com a liberação, o medicamento, que já era usado nos tratamentos de câncer de mama e ovário, poderá ser indicado a pacientes com uma mutação genética específica, em casos em que a doença se espalhou além do pâncreas, mas não se agravou após, pelo menos, dezesseis semanas de tratamento com quimioterapia.
A medida de liberação do medicamento segue uma recomendação do Comitê Consultivo de Drogas Oncológicas do FDA, que teve como base os resultados de um estudo científico publicado na revista The New England Journal of Medicine.
Na pesquisa, 154 pacientes com a doença foram submetidos ao tratamento com o Lynparza. O estudo concluiu que o medicamento quase dobrou o tempo de sobrevida.
Vale ressaltar que, no Brasil, o órgão responsável pela liberação de medicamentos é a Agência Nacional de Vigilância Sanitária (Anvisa). Por hora, não há previsão sobre a liberação do produto no País.
Em abril de 2017, a Anvisa aprovou o medicamento Abraxane, que consiste na associação nanotecnológica entre o paclitaxel e a albumina. A autorização foi para a forma farmacêutica em pó liofilizado para suspensão injetável, na concentração de 100 mg.
O medicamento é indicado para tratamento em primeira linha de pacientes com adenocarcinoma de pâncreas metastático, doença rara de comportamento agressivo e alta taxa de mortalidade.
Câncer de pâncreas no mundo
De acordo com o levantamento da União Internacional Contra o Câncer (UICC), os casos de tumores de pâncreas aumentam de forma significativa conforme as pessoas têm mais idade.
Os dados apontaram uma estimativa de 10 casos para 100 mil habitantes, entre 40 e 60 anos. No caso de pessoas com 80 a 85 anos, os números aumentam para 116 casos para cada 100 mil idosos.
Segundo o Instituto do Câncer (Inca), o câncer de pâncreas mais comum é do tipo adenocarcinoma (que se origina no tecido glandular), correspondendo a 90% dos pacientes diagnosticados. Nesses casos, a doença afeta o lado direito do órgão.
Por ser um câncer de difícil detecção, os tumores de pâncreas apresentam alta taxa de mortalidade, justamente, devido ao diagnóstico tardio. No Brasil, a doença é responsável por cerca de 2% de todos os tipos de cânceres. Além disso, ela é responsável por 4% das mortes causadas desse mesmo total.
Novos estudos
Um recente estudo realizado na Universidade de Tel Aviv, em Israel, publicado no início de dezembro de 2019, descobriu uma molécula pequena que tem a capacidade de induzir a autodestruição de células cancerígenas do pâncreas.
Na pesquisa, os cientistas conseguiram reduzir o número de células da doença em 90%, no caso de tumores desenvolvidos um mês após administração do xenoenxertos – transplantes de câncer de pâncreas humano para camundongos imunocomprometidos.
Apesar de ainda ser muito precoce, tendo que passar por várias etapas de testes, o estudo repercutiu em muitos sites em todo o mundo e levantou expectativas sobre futuras formas de tratamento para combater a doença.